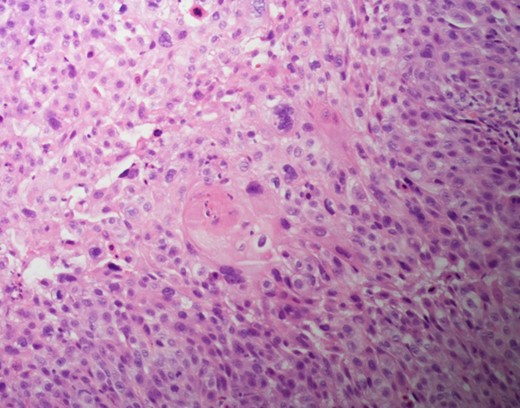
Hematoxylin and eosin staining shows squamous cell cancer.

-
PDF
- Split View
-
Views
-
Cite
Cite
Nirupama Anne, Elisabeth Sulger, Ratnakishore Pallapothu, Primary squamous cell carcinoma of the breast: a case report and review of the literature, Journal of Surgical Case Reports, Volume 2019, Issue 6, June 2019, rjz182, https://doi.org/10.1093/jscr/rjz182
Close - Share Icon Share
Abstract
Primary squamous cell carcinoma of the breast is a rare tumor. The prognosis is poor, and hence there is a clinical trend to offer multi-modal treatment options of surgery, chemotherapy, and radiation therapy. There is no consensus on treatment options due to the paucity of available data. We are reporting the case of a 68-year-old lady who presented with a right breast mass. Upon core biopsy and further workup, she was noted to have primary squamous cell carcinoma of the breast. She was successfully treated with surgical therapy alone without disease recurrence at 36 months. Primary squamous cell carcinoma of the breast can be treated successfully with surgical therapy alone. The role of adjuvant chemotherapy, radiation therapy, and anti-estrogen therapy should be questioned as these modalities can lead to significant treatment-related morbidities and might not be contributing to disease-free interval or overall survival from this unusual tumor subtype.
INTRODUCTION
Primary squamous cell carcinoma (SqCC) of the breast is a rare malignancy that accounts for less than 0.1% of invasive breast cancers. [1] This type of tumor is theorized to develop from squamous metaplasia in ductal carcinoma cells. [2, 3] The diagnosis is determined when 90% of malignant cells are of squamous type. [4] The tumors are described as aggressive, hormone receptor negative, and treatment-refractory with a poor prognosis. Since the first recorded case in 1908, few reports of primary SqCC of the breast have been published and clinical management has yet to be standardized.
CASE REPORT
A 68-year-old postmenopausal Caucasian woman was referred for a palpable right breast mass. She denied history of breast masses or issues. She did not undergo a screening mammogram in four years.
Physical examination revealed a palpable right breast mass located at 12 O’clock, 6 cm from the nipple. It was 3 cm × 2 cm in size, freely mobile, firm, and non-tender. There was no associated skin puckering or edema. There were no other palpable breast masses, no palpable axillary, supra-clavicular, or infra-clavicular lymph nodes.
A diagnostic mammogram and ultrasound were performed to evaluate the right breast mass. The right breast imaging was categorized as BIRADS 5 (Figs 1–3). The patient underwent a right breast ultrasound-guided vacuum core biopsy of the mass and a fine needle aspiration (FNA) of the enlarged lymph node in the right axilla. Pathology of the core biopsy revealed poorly differentiated squamous cell carcinoma with tumor necrosis and calcification (Figs 4 and 5). Cytology of the right axillary lymph node was negative for metastatic carcinoma.

Right breast cranio-caudal and mediolateral oblique mammographic views, demonstrate a smooth, well rounded, mammographic density, corresponding to the palpable right breast mass. In addition, a prominent right axillary lymph node is noted in the mediolateral oblique view.

Right breast cranio-caudal and mediolateral oblique mammographic views, demonstrate a smooth, well rounded, mammographic density, corresponding to the palpable right breast mass. In addition, a prominent right axillary lymph node is noted in the mediolateral oblique view.

Right breast ultrasound demonstrates an irregular shaped, hypoechoic solid mass, located adjacent to the pectoralis muscle. This corresponds to the abnormal mammographic density noted in Figures1 and 2 and to the palpable abnormal finding on the clinical breast exam.

Cytokeratin 5/6 staining is positive which indicates the cells to be of squamous origin.
The patient underwent PET/CT scan to rule out sources of primary or metastatic lesions. PET/CT scan showed abnormal hypermetabolic area at the site of the right breast mass. No suspicious nodules of lung parenchyma were found.
Pathology slides from the right breast mass core biopsy and fine needle aspirate from the right axillary lymph node were sent to Memorial Sloan Kettering for a second opinion, and the diagnosis of primary squamous cell carcinoma of the breast was reaffirmed. The patient received a second breast oncology opinion at Memorial Sloan Kettering and decided to proceed with surgical care locally.
She underwent a right total mastectomy with a right axilla sentinel lymph node biopsy. Final pathology showed the right breast mass to be 3.5 cm × 3.4 cm, comprised of poorly differentiated keratinizing squamous cell carcinoma with necrosis. There was no involvement of the skin, nipple, or skeletal muscle. The tumor was estrogen receptor negative, progesterone receptor negative, Her2/neu negative, 40–50% Ki67 index, and strongly positive for Cytokeratin 5/6. The sentinel lymph node showed reactive follicular cells and no evidence of squamous cell carcinoma. Following surgical intervention, the patient declined further chemotherapy or radiation therapy. She was followed with clinical surveillance. She is clinically doing well, 36 months following her initial diagnosis, with no evidence of disease recurrence.
DISCUSSION
Primary squamous cell carcinoma of the breast is a rare and aggressive type of cancer. It is theorized to arise from squamous metaplasia of ductal carcinoma cells or mammary duct epithelium. [2, 3, 5] Metastasis of SqCC to the breast from other organs, such as the lungs, stomach, or skin, is more common compared to primary squamous cell carcinoma of the breast. [2, 6] SqCC usually presents in postmenopausal women, [7, 8] however has been reported in young women. [7, 9] SqCC tumors are larger than breast adenocarcinomas and have been reported to be up to 8 cm in size [7, 9, 10].
There are no specific mammogram or ultrasound characteristics of primary SqCC. In our case, the diagnostic mammogram showed a smooth, well-rounded density whereas the same mass appeared to be irregularly shaped on ultrasound. Diagnosis can only be confirmed through a core needle biopsy. Tissue samples show sheets of malignant squamous cells with intercellular bridges (as seen in this case, Fig. 4) and keratin formation. [4, 5, 7] The Cytokeratin staining for 5/6 is positive, which indicates the tumor to be of squamous origin (as in this case, Fig. 5). The tumor is usually estrogen and progesterone receptor negative without overexpression of Her2/neu, as noted in this patient. It is typically high grade, although lymph node involvement is less common with SqCC than breast adenocarcinoma. Seventy percent of patients with SqCC have no axillary lymph node involvement [3].
Additionally, in order to confirm a diagnosis of primary SqCC, the tumor must meet the following criteria: [2, 10]
No other neoplastic changes other than squamous cell carcinoma.
No other primary site of SqCC.
No involvement of overlying skin or nipple.
In this case, the patient met all the criteria. Other primary sites of SqCC were ruled out with the metastatic work up. The tumor was estrogen, progesterone, and Her2/neu receptors negative and stained positively for Cytokeratin 5/6.
Due to the low incidence, the treatment of primary SqCC of the breast is yet to be standardized. Current treatment strategies for primary SqCC are extrapolated from treatment paradigms for invasive ductal and lobular breast cancers. In this case, surgical treatment was provided as the patient did not wish to pursue adjuvant chemo-radiation. There are reported cases where patients underwent multi-modal approach involving surgery, adjuvant systemic chemotherapy, radiation, and anti-estrogen blockade. However, the efficacy of these treatments is still unclear due to paucity of data. SqCC of the breast has been reported in some cases to be radio-resistant and in other cases to be radio-sensitive. [5, 6] It is not responsive to chemotherapeutic agents typically used for the treatment of invasive ductal carcinoma. [6] Aparicio et. al. noted that there was no survival benefit in SqCC patients who received neoadjuvant or adjuvant chemotherapy, in comparison to those who did not receive chemotherapy [10]. Considering that most SqCC patients are hormone receptor negative, the hormone blockade may also be ineffective.
Prognosis remains unclear. Some cases have reported outcomes similar to poorly differentiated breast carcinoma, with low overall survival rate. In this case however, the clinical course was relatively favorable with primary surgical treatment alone and resulted in no evidence of disease recurrence at 36 months. This case unveils that surgical intervention alone can result in a favorable disease-free interval. More data is necessary to formulate management guidelines and further define if there is any role for systemic chemotherapy, radiation therapy, or hormonal blockade.
CONFLICT OF INTEREST STATEMENT
None.
ETHICS APPROVAL AND CONSENT TO PARTICIPATE
Our Lady of Lourdes Hospital Institutional Review Board Chair person provided an exemption for the publication.
CONSENT FOR PUBLICATION
Written informed consent was obtained from the patient prior to the submission of the report. The signed Institutional Consent Form is on-file.
FUNDING/FINANCIAL CONFLICTS
None.
AUTHOR’S CONTRIBUTIONS
NA collected case information, images, slides, contributor in writing the manuscript. ES collected background information, contributor in writing the manuscript. RP contributor in writing the manuscript, editing. All authors read and approved the final manuscript.